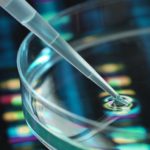

Home Search
- search results
If you're not happy with the results, please do another search
ECG to begin meter audit from August 1
The Electricity Company of Ghana (ECG) will from August 1 commence customer meter audit as part of measures to clamp down on illegal connection...
WHO urges reduction in number of sexual partners as monkeypox surges
As monkeypox cases surge globally, the World Health Organisation (WHO) has called on the group currently most affected by the virus – men who...
Two high schools clash at basketball competition; NSS person attacked
A National Service Person with the St. Mary's Boys Senior High School at Apowa in the Ahanta West District of the Western Region is...
Why Ofankor-Nsawam tollbooth is being renovated [Audio]
JoyNews/AdomNews · Ofankor- Nsawam tollbooth renovation is for future purposes - Deputy Roads Minister
It has emerged government is rehabilitating and expanding the tollbooth on...
Police being perceived as corrupt very discouraging – Retired officer
Superintendent Paul Mensah Bampoh, a retired officer, has backed the Ghana Police Service over its response to the Afro barometer survey on corruption.
The Ghana...
2022 World Cup: Sad news hits France and Juventus midfielder Paul Pogba
Reports in Italy suggest that Paul Pogba’s knee injury could force him to miss next season’s Qatar World Cup.
Pogba will see a specialist consultant...
2022 WC: Checkout beautiful pictures of Black Stars’ team hotel in Qatar
Black Stars will lodge at the Double Tree by Hulton Doha-Al Sadd Hotel and train at the Aspire Zone training facilities 1 during their...
I’m scared – Akufo-Addo’s appointee ‘cries’ after thieves broke into his home
The Kwadaso Municipal Chief Executive (MCE), Richmond Agyenim Boateng, says he is living in fear after unidentified thieves broke into his home.
The unfortunate incident...
First grain ship to leave Ukraine after Russia deal
The first grain ship from Ukraine since Russia's invasion could leave port as early as Friday, but "crucial details" are still being ironed out,...
Ukraine War: Blast kills 40 Ukrainian prisoners
Russia's defence ministry says 40 Ukrainian prisoners-of-war have been killed by Ukrainian shelling of a prison in separatist-held Donetsk.
Officials alleged that 75 others had...
Tears flow as Kumawood actors pay last respects to colleague Osei Tutu
Kumawood actors on Thursday united to pay their final respects to their fallen colleague, Nana Osei Tutu.
The thespians, mostly males, thronged Sakora Wonoo in...
Bride reads cheating fiancé’s texts to wedding guests instead of vows
An Australian bride is being hailed a hero on her wedding day after an anonymous text message was sent the night before her wedding revealing...
I would return to prison if I am not re-integrated – Ex-convict
An ex-convict, Samuel Nkrumah, who served a five-year sentence at the Awutu Camp Prison, says he wants support to become a professional driver as...
Duncan Williams’ son spotted chilling at party
Daniel Duncan Williams, son of famous Ghanaian preacher, Nicholas Duncan Williams, has been spotted at a party having a good time.
The Narcos Black...
The People’s Forum: Transport fares killing our businesses – Madina market women cry
Market women at Madina in Accra are lamenting over the continuous increase in fuel prices.
They claim transportation has increased and their capital is being...
Meet the child who conquered US, Germany, others in Mathematics competition
A Senior Secondary School one (SSS1) student, Uwakmfon Unwana Jacob, is the latest Nigerian kid that has put smiles on the faces of Nigerians...
Magistrate abandons official bungalow over ‘galamsey’ activities
The Magistrate of the Nkroful District Court has reportedly relocated from her official bungalow due to the disturbing activities of illegal miners close by.
This...
Anger over pro-Putin chants at Turkey football march
Ukrainian officials have condemned Turkish football fans who chanted Russian leader Vladimir Putin's name at a Champions League clash in Istanbul.
Thousands of Fenerbahce supporters...
US economy shrinks, sparks recession fears
The US economy has shrunk for the second quarter in a row, a milestone that in many countries would be considered an economic recession.
That...
Former Rector of Tamale Technical University passes on
A former Rector of the Tamale Technical University (TATU), Professor Peligah Yakubu Seidu, has been reported dead.
Though the cause of death is not...
Haiti crisis: Gun battles rage in Haiti’s capital
A war between Haitian gangs which has left hundreds dead since it flared up three weeks ago has spread to the centre of the...
Heart gene therapy to stop young sudden death risk
Scientists say they should soon be able to effectively cure inherited, life-threatening heart muscle conditions to save more young people from sudden cardiac death.
The...
China signals it could miss economic growth target
China has signalled that it may miss its annual economic growth target, as Covid restrictions weigh on the world's second largest economy.
On Thursday, the...
Ex-child bride among 3 women executed for murdering their husbands
Iranian authorities put three women to death on Wednesday for murdering their husbands, a human rights charity says.
According to the Iran Human Rights Group...
Man allegedly inflicts cutlass wounds on girlfriend for denying him sex
A man has allegedly inflicted cutlass wounds on his partner at Bepong in the Kwahu South District of the Eastern Region.
The 40-year-old suspect, reportedly,...
Govt inflates new BOST office construction by 100% – Minority alleges
The Minority in Parliament has alleged that government has padded the contract sum meant for an office space for the Bulk Oil Storage and...
Countries with cheapest mobile data: Where does Ghana rank?
Ghana has made it onto the list of countries with the cheapest mobile data in the world.
This conclusion came from a survey conducted by The...
Supreme Court strikes out law on cultivation of ‘wee’ in Ghana
The Supreme Court has declared as unconstitutional the law which permits license to be granted for the cultivation of cannabis or ‘wee’ in small...
Sehwi Proso chief linguist shot dead in forest
A chief linguist of Sehwi Proso traditional area in the Juaboso District has allegedly been shot dead in a forest by unidentified persons.
It...
Horrifying details of why midwives refused to cut umbilical cord for lady who delivered...
Imagine delivering a premature baby at home during the Covid-19 lockdown and walking to the nearest polyclinic with the baby’s umbilical cord uncut and...
Barcelona reach agreement with Sevilla for Jules Kounde
Barcelona have agreed to sign France centre-back Jules Kounde from Sevilla for a reported transfer fee of 50m euros (£41.85m).
However, Barca say the deal is subject...
Stop twerking on social media – Nurses and midwives advised
The Chief Nursing and Midwifery Officer for Bono Region, Madam Emily Ama Oduro, has advised nurses and midwives to avoid abusing social media by...
Court remands police officer, KNUST student accused of rape
The Asokore Mampong District court has remanded a police officer, Lance Corporal Frank Adu Poku and a final year student of the Kwame Nkrumah...
Giant screen falls on dancers at concert
A giant screen fell and injured two dancers in front of horrified fans at a concert in Hong Kong by the hugely popular boy...
Chilling account of how a policeman and KNUST student allegedly gang-raped female student and...
A police officer stationed at Bomso and a student of the Kwame Nkrumah University of Science and Technology (KNUST) have been arrested for allegedly gang-raping...
PL player no longer being investigated by police over 1 of 3 rape allegations
A Premier League player arrested on suspicion of rape is no longer being investigated by police over one of the three alleged incidents.
The 29-year-old,...
Community Shield Preview: Manchester City v Liverpool
SuperSport viewers on DStv can look forward to the English season’s traditional season-opening fixture, the FA Community Shield, which sees FA Cup champions Liverpool...
Newly married banker shot dead as robbers attack bullion van
Friends and family are mourning one Igwe O Igwe, a banker who was shot dead by armed robbers during a bullion van robbery.
The deceased...
GES shuts school after gang forced teacher to kneel and beg for punishing students
The Akyem Anyinasin Methodist Junior High School (JHS) in the Abuakwa North Municipality of the Eastern region has been closed down by the Ghana...
Only selfish pastors, politicians support ‘bogus’ National Cathedral – Prophet Kumchacha [Video]
Prophet Kumchacha has lambasted pastors and politicians who are advocating for the building of the National Cathedral in Ghana.
According to him, he doesn't...



![Why Ofankor-Nsawam tollbooth is being renovated [Audio] toll booth](https://www.adomonline.com/wp-content/uploads/2021/02/download-Copy-150x150.jpg)

![Only selfish pastors, politicians support ‘bogus’ National Cathedral – Prophet Kumchacha [Video]](https://www.adomonline.com/wp-content/uploads/2022/07/sddefault-7-150x150.jpg)